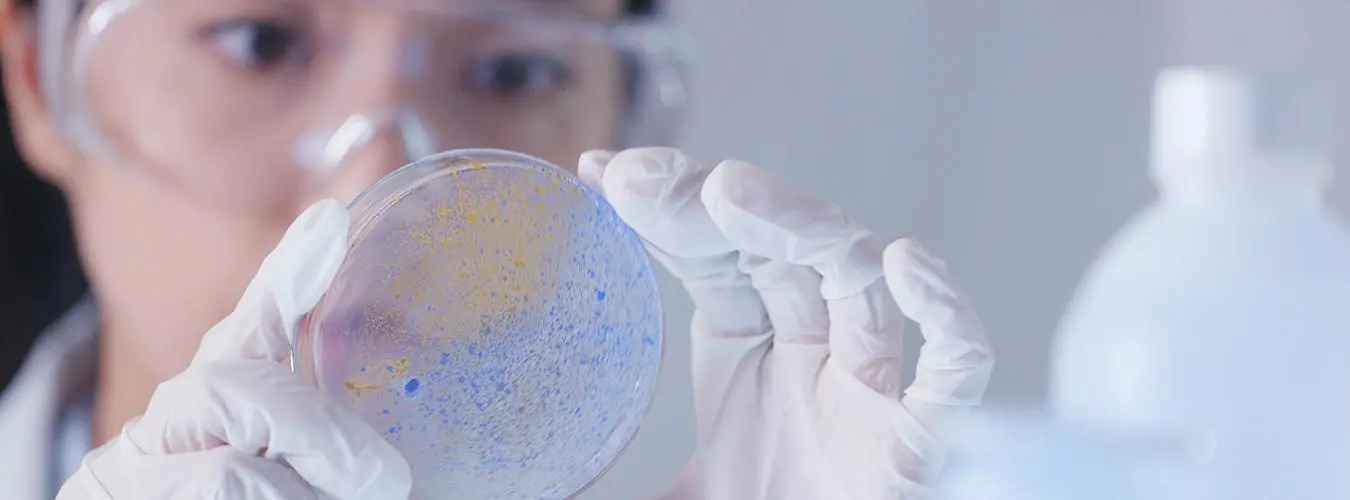

- This event has passed.
International Day of Women and Girls in Science 2026
11 February All day
On 22 December 2015, the General Assembly decided to establish an annual International Day to recognize the critical role women and girls play in science and technology, through Resolution A/RES/70/212.
The International Day of Women and Girls in Science, celebrated on 11 February, is implemented by UNESCO and UN-Women, in collaboration institutions and civil society partners that aim to promote women and girls in science. This Day is an opportunity to promote full and equal access to and participation in science for women and girls. Gender equality is a global priority for UNESCO, and the support of young girls, their education and their full ability to make their ideas heard are levers for development and peace.
Innovate. Demonstrate. Elevate. Advance. Sustain. ( I.D.E.A.S.)
Bringing Everyone Forward for Sustainable and Equitable Development
This year, the International Day of Women and Girls in Science (IDWGIS) will focus on the role of Women and Girls and Science as relates to the Sustainable Development Goals(SDGs) in review at the forthcoming High-Level Political Forum (HLPF), namely SDG 6 (clean water and sanitation), SDG 7 (affordable and clean energy), SDG 9 (industry, innovation, and infrastructure), SDG 11 (sustainable cities and communities) and SDG17 (means of implementation), while following up on discussions on water held during from the “Water Unites Us” 7th IDWGIS, the 2nd High-Level International Conference on the International Decade for Action on Water for Sustainable Development 2018-2028, held in Dushanbe, and the 2nd UN Ocean Conference and its High-Level Symposium on Water held in Lisbon, as a contribution for the 2023 UN Water Conference, and other UN Fora.
In doing so the IDWGIS aims to connect the International Community to Women and Girls in Science, strengthening the ties between science, policy, and society for strategies oriented towards the future. The IDWGIS will thus showcase best practices, strategies, applied solutions in addressing SDGs challenges and opportunities. It will also include for the first time a science workshop for Blind Girls and a session from the BLIND fellow SCIENTISTS on “Science in Braille: Making Science Accessible”.
